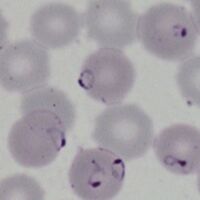

Plasmodium falciparum: Morphology: Difference between revisions
From haematologyetc.co.uk
No edit summary |
No edit summary |
||
| Line 87: | Line 87: | ||
*[[Schizont Development|Schizonts]] develop progressively to form 8-16 merozoites when mature | *[[Schizont Development|Schizonts]] develop progressively to form 8-16 merozoites when mature | ||
*In this species the loose [[Malaria pigment|malaria pigment]] may be seen in clumps between the parasites | *In this species the loose [[Malaria pigment|malaria pigment]] may be seen in clumps between the parasites | ||
*Red cell size is generally unaffected but | *Red cell size is generally unaffected but red cells become pale as haemoglobin is metabolised by the parasites | ||
Revision as of 20:11, 1 April 2024
Navigation
(click blue highlighted text to return to page)
Malaria main index
>Species identification: summary page
>>This page: P.falciparum: morphology
| The early trophozoite |
The earliest growth stage, and may be the only form seen in this species:
- Ring forms that are fine and delicate
- Frequently the red cells contain multiple parasites
- Parasites may have a distinctive "double dot" or signet ring form
- Parasites may appear on the accolé forms that appear flattened against the cell membrane
- Affected red cells have normal size and haemoglobin content
| The late trophozoite |
The later growth stage:
- Parasites resemble early ring forms, but are thicker and may be slightly larger
- Additional blue/grey dots and clefts are seen in red cell cytoplasm when stained correctly
- These dots have low number a characteristic "dot" or "line" form Maurer's dots and clefts
- Size and shape of infected red cells is usually unaffected, but may become crenated
- The double dot, accolé, and multiple parasite forms remain present
| The schizont |
The asexual form:
- Do not generally circulate in this species unless overwhelming infection
- The asexually formed developing "merozoites" cluster untidily
- Schizonts develop progressively to form 8-16 merozoites when mature
- In this species the loose malaria pigment may be seen in clumps between the parasites
- Red cell size is generally unaffected but red cells become pale as haemoglobin is metabolised by the parasites
The gametocyte
| The gametocyte |
The sexual replication form (very distinctive).
- Gametocytes are elongated but are restricted into typical shape by the red cell membrane
- They parasites are rod shaped but the membrane may cause them to curve into a “"banana" form”
- The residual membrane (empty of haemoglobin) is often seen as a "blister" to the side of the parasite
- The single chromatin area is in the centre of the parasite, often has pigment overlying it
- Gametocytes may not be be seen, or may be the only form present (particularly after treatment)